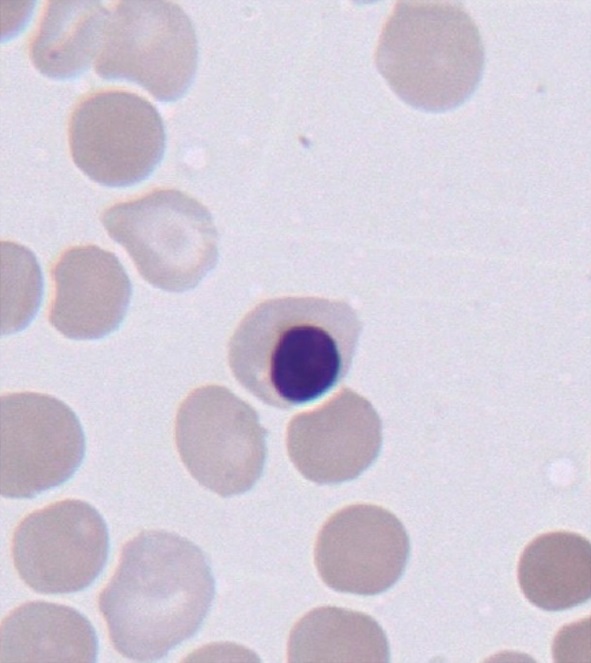
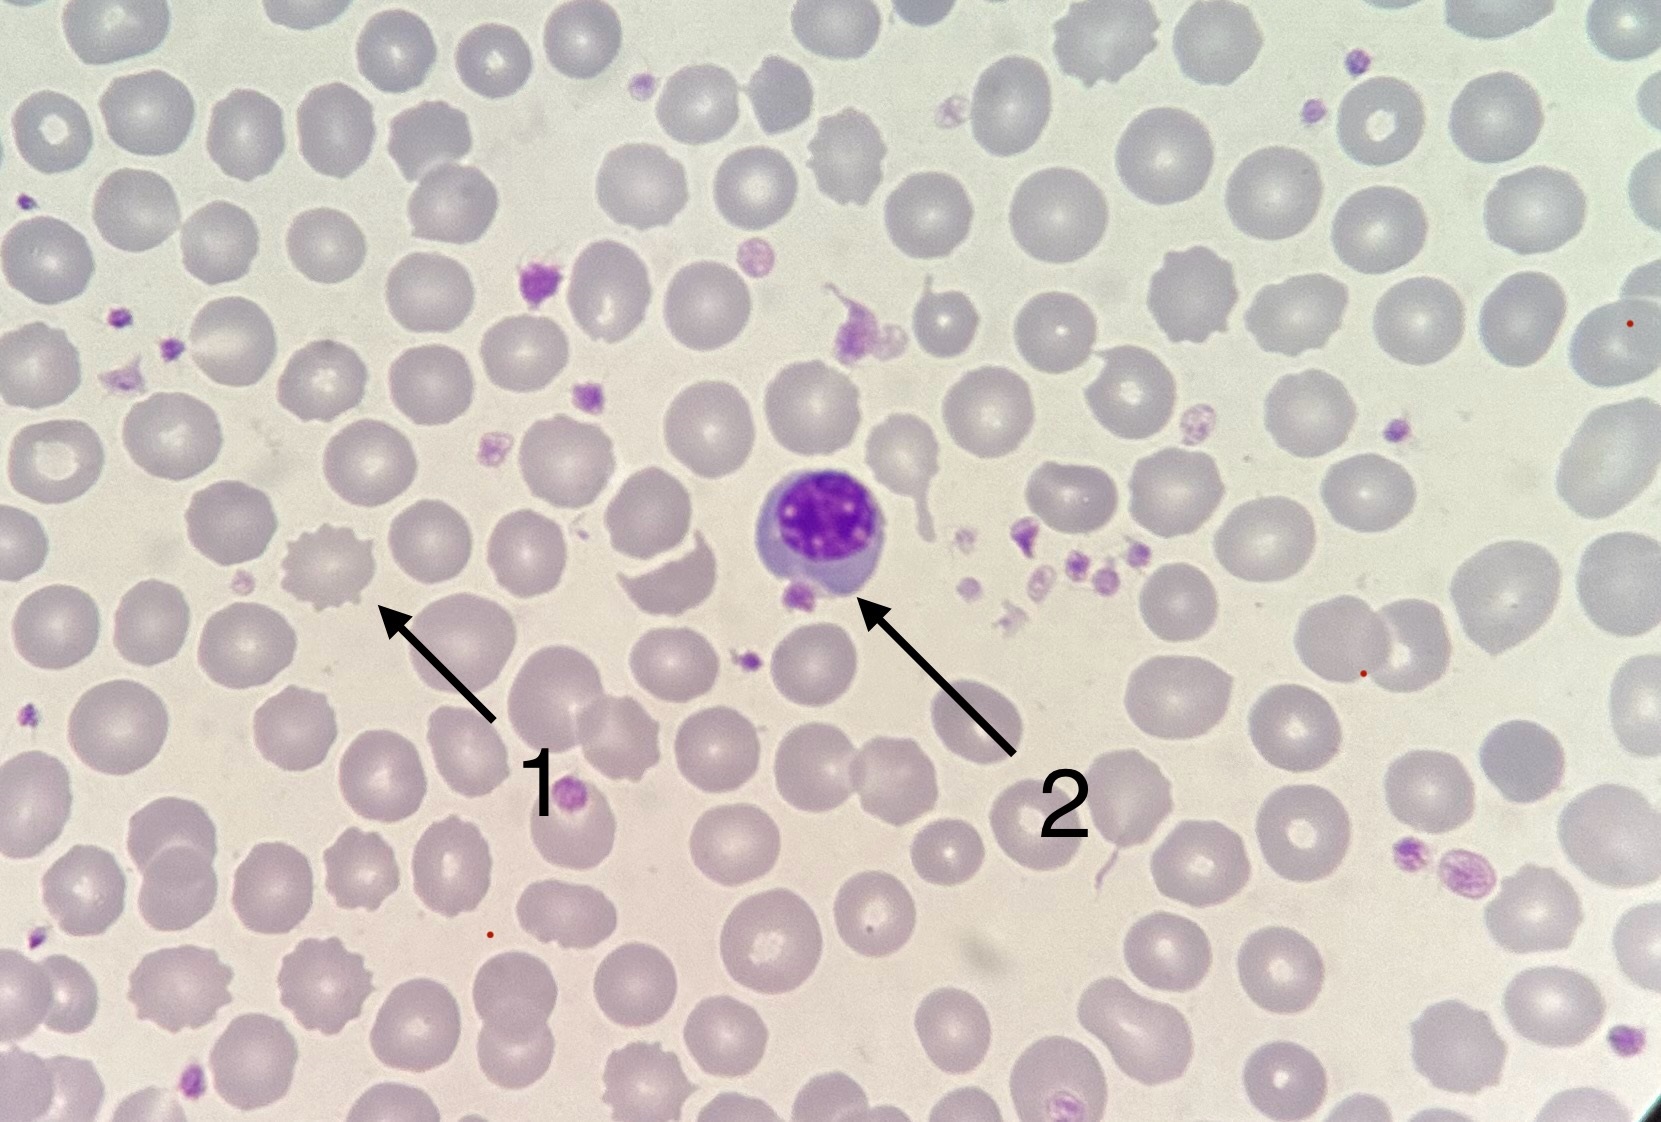

Нормобласты форум
По настоящему привлекало
Получение информации о соединениях абонентов
В почках моча что это
Заржавел кран
Фото красивых стрижек коротких волос
Стеллажи в погреб сделать
История триколора российского флага кратко
Доверенность начальника колонии
Обучаемый ключ калина
Сколько варить свежие лисички
Шаблоны детских журналов
Arena breakout хранилище
Аббасова г
Нормобласты форум 110 фото